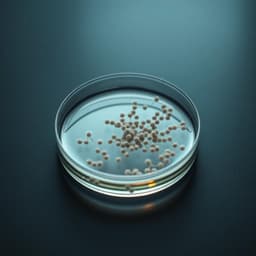
Microbiome Therapeutics Tracker

Microbiome Therapeutics Tracker · Mar 19 Daily Digest
Gut-Brain Axis Research
- 🔥 UC Santa Barbara Grant: UC Santa Barbara received a grant from Wellcome Leap to investigate early-life gut microbiome...
Created by Sungwuk Choi
Updates on human microbiome research, disease links, clinical trials, and biotech startups
Explore the latest content tracked by Microbiome Therapeutics Tracker
Key mechanisms from fiber-driven gut health:
Key breakthroughs in AI-driven gut health ingredients:
Key mechanistic insights from ISB's microSPLiT analysis of Bacteroides fragilis:
Roseburia inulinivorans, a strain-specific gut bacterium, is causally linked to increased muscle strength in both people and mice via amino acid depletion.
The gut microbiome significantly influences serotonin biosynthesis across the lifespan, with fluctuations reflecting parallel changes in serotonin levels—highlighting the microbiome-serotonin axis in systemic health.
A new study investigates distinct oral microbiota profiles in head and neck cancer patients and their potential as diagnostic and prognostic signatures – spotlighting non-gut niches for cancer biomarkers.
Roswell Park breakthrough: Specific gut bacteria correlate with superior, longer-lasting immunotherapy responses in 40 ovarian cancer patients.
-...
Key insights on Akkermansia muciniphila in cancer defense:
Gut-targeted prebiotic inulin shows clinical promise for knee osteoarthritis relief:
Converging evidence cements causal gut-brain routes for neuro disorders, spotlighting microbiome targets:
Translational win: Clinical trial shows inulin supplements eased knee arthritis pain, improved grip strength, and cut pain sensitivity in 117 patients...
MIT scientists discovered intelectin-2, a little-known gut protein that traps and kills dangerous bacteria while playing a powerful double role in defending the gut. Vital mechanistic insight for microbiome therapeutics.
Emerging gut-muscle axis target for sarcopenia:
Direct gut-to-brain bacterial translocation via vagus nerve revealed in mice on high-fat Paigen diet, linking gut permeability to neurodegeneration...